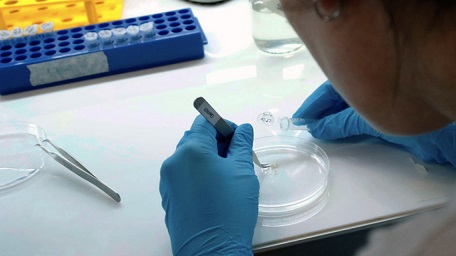

Panaderos chaqueños anticipan un nuevo aumento entre el 5 y el 10 por cientoEn caída libre: el 65% de los argentinos desaprueba la gestión de MileiNuevo Chaco Fondos: solución eficiente para inversores conservadores que buscan hacer rendir su dineroZdero inauguró la nueva Comisaría Sexta en Sáenz Peña y remarcó el avance en seguridad juvenilCon el pago de salarios, choferes de la UTA suspendieron el paro